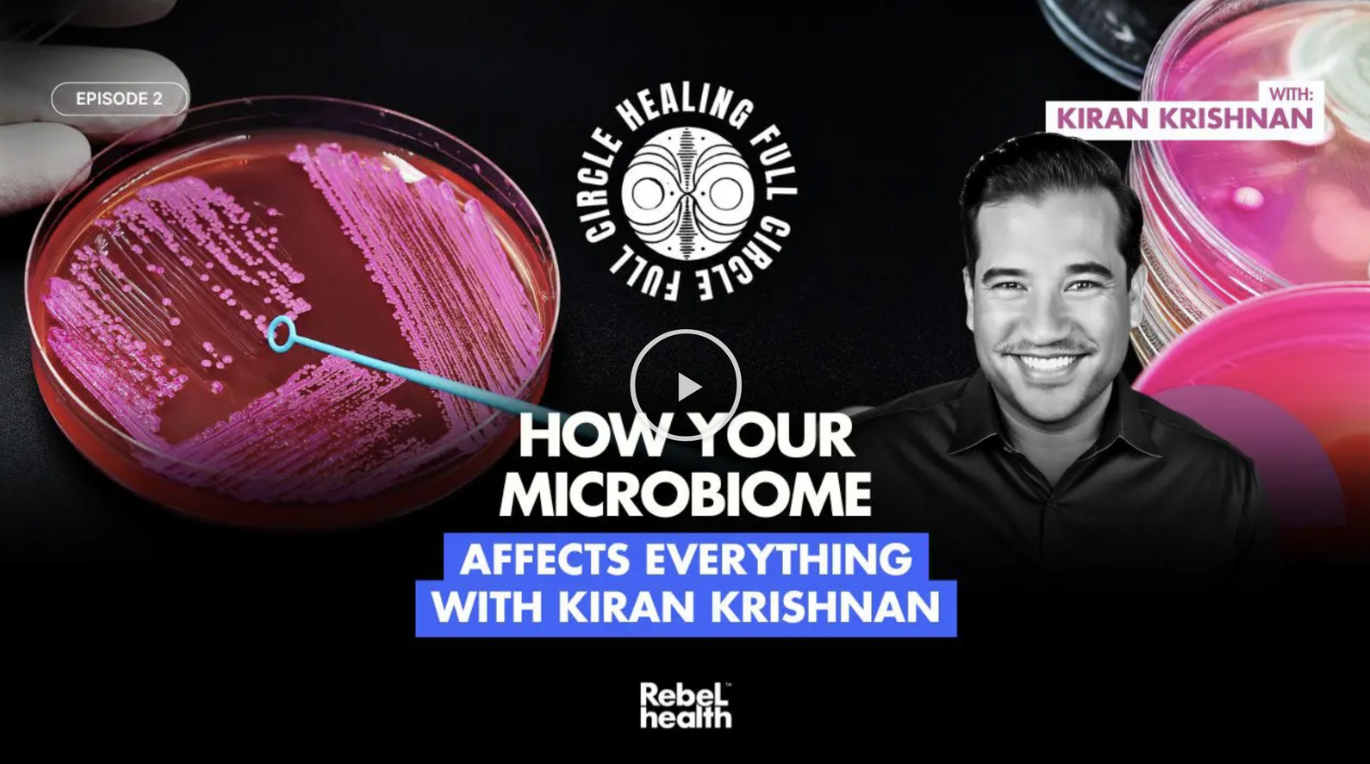

MY LATEST PODCASTS & VIDEOS
LATEST PODCAST ON GUT HEALTH
The #1 Reason People Die (You’ll Be Surprised!) & How To ARM Your Gut So It Doesn’t Happen To YOU!
LATEST PODCAST ON Leaky Gut & Immunity
Discover how your gut microbiome impacts your hormones, immunity, and overall well-being.
LATEST PODCAST ON THE MICROBIOME
How Your Microbiome Affects EVERYTHING with Microbiologist Kiran Krishnan!
LATEST PODCAST ON THE GUT-BRAIN AXIS
How To Improve Your Memory & Focus Ft. Just Thrive Founder, Tina Anderson & Kiran Krishnan